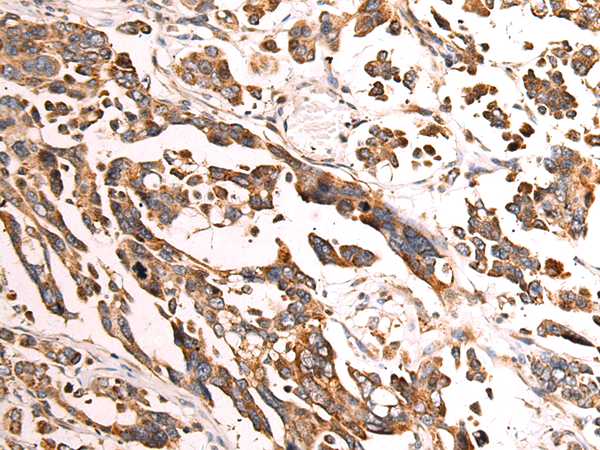
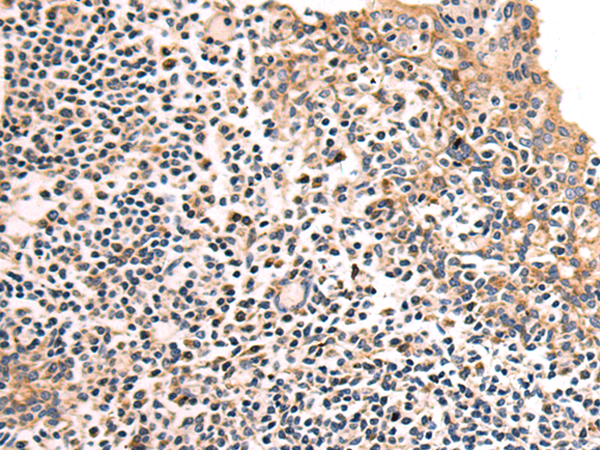

-
分类: 科研抗体货号: P09901别名: HRB2; RIP-1应用: WB,IHC反应种属: Human, Mouse
-
分类: 科研抗体货号: P09919别名: DAP; ASPEP应用: IHC反应种属: Human, Mouse
-
分类: 科研抗体货号: P09900别名: ESA; ECS1; ESA1; ECS-1; M17S1应用: WB,IHC反应种属: Human, Mouse, Rat
-
分类: 科研抗体货号: P09918别名: p55; Rpn5; STISS应用: WB,IHC反应种属: Human, Mouse, Rat
-
分类: 科研抗体货号: P09899别名: FDH; ADHX; ADH-3; FALDH; GSNOR; GSH-FDH; HEL-S-60p应用: WB反应种属: Human, Mouse, Rat
-
分类: 科研抗体货号: P09916别名: ERA; CEGA; ERA-W; H-ERA; ERAL1A; ERAL1B; HERA-A; HERA-B; PRLTS6应用: IHC反应种属: Human
-
分类: 科研抗体货号: P09927别名: PP2CG; PPP2CG; PP2CGAMMA应用: IHC反应种属: Human, Mouse, Rat
-
分类: 科研抗体货号: P09915别名: OAS应用: IHC反应种属: Human, Mouse
-
分类: 科研抗体货号: P09926别名: AYTL1; AGPAT11; LysoPAFAT应用: WB,IHC反应种属: Human, Mouse, Rat
-
分类: 科研抗体货号: P09913别名: S5mt; MRP-S5应用: WB,IHC反应种属: Human, Mouse, Rat

鄂公网安备42018502007531号
鄂公网安备42018502007531号

